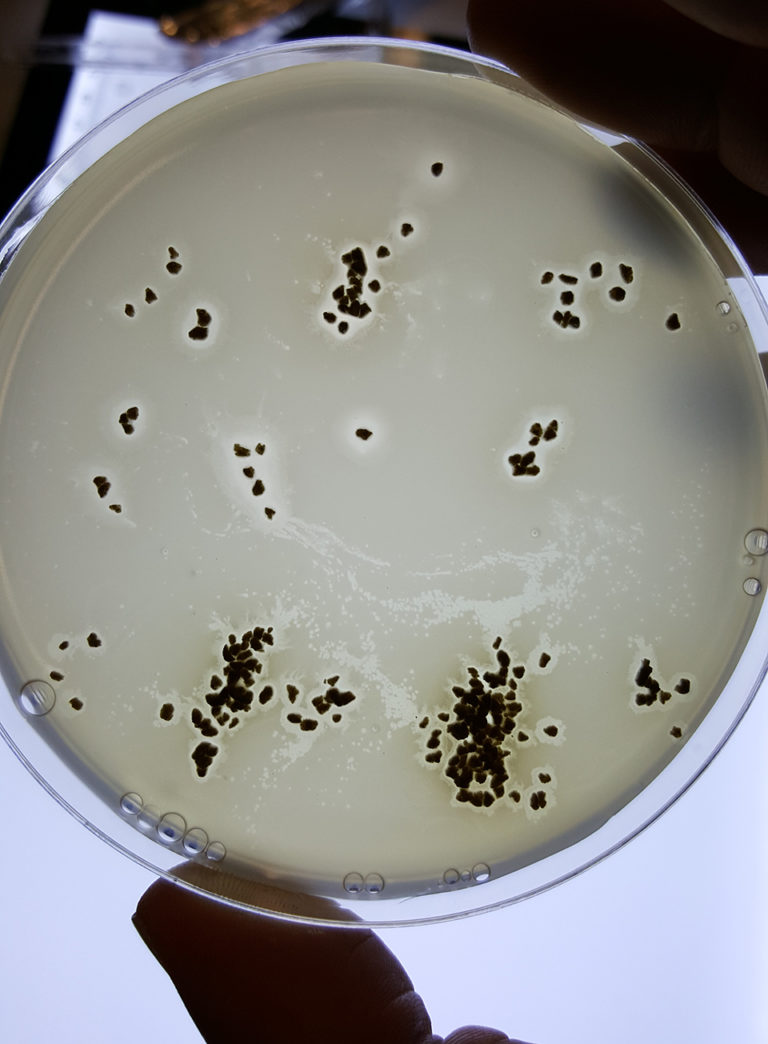

Innovation & Investment
Scottish firm honing bacteriophages into aquaculture-disease assassins
Scottish biotech firm Fixed Phage aims to bottle the powers of bacteriophages to deploy these “bacteria killers” on some of the world’s most destructive aquaculture diseases.